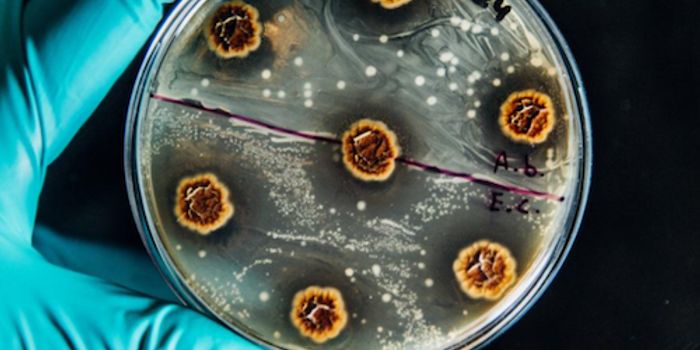
Treatment Strategies for Multidrug-resistant Chronic Infections

Molecular Diagnostics
Molecular Diagnostics: Molecular diagnostic tests detect specific sequences in DNA or RNA that may or may not be associated with disease, including single nucleotide polymorphism (SNP), deletions, rearrangements, insertions and others. By analysing the specifics of the patient and their disease, molecular diagnostics offers the prospect of personalized medicine. These tests are useful in a range of medical specialisms, including infectious disease, oncology, human leucocyte antigen typing, coagulation, and pharmacogenomics-the genetic prediction of which drugs will work best.
-
APR 16, 2018Genetics & GenomicsThis discovery could help show why some people are more prone to developing the disorder.Written By: Carmen LeitchAPR 15, 2018Drug Discovery & DevelopmentA study published in Nature Medicine examines a monoclonal antibody isolated from the blood of individuals vaccinated fo ...Written By: Nouran AminAPR 11, 2018CardiologyThere’s a new biomarker in the world of science that finally links heart disease and diabetes on the molecular lev ...Written By: Kara MarkerAPR 10, 2018CancerA group in South Korea are conducting a clinical trial to evaluate a diagnostic screening tool for gastric cancer using ...Written By: Mauri BrueggemanAPR 06, 2018CancerThe Cancer Genome Atlas project used genomic profiles and bioinformatics to catalogue 33 prevalent types of cancer and i ...Written By: Mauri BrueggemanAPR 06, 2018Clinical & Molecular DXDiagnostic tests for Lyme disease, or Lyme neuroborreliosis (LNB) can take up to a week, but patients affected need anti ...Written By: Kara MarkerAPR 04, 2018CancerA group of researchers have proposed a new risk grouping model to more accurately/precisely predict the risk of prostate ...Written By: Mauri BrueggemanMAR 29, 2018Clinical & Molecular DXA potential new diagnostic test for kidney damage associated with antibiotic use in cystic fibrosis (CF) patients is abl ...Written By: Kara MarkerMAR 28, 2018CardiologyDiagnostic electrodes for measuring electrical impulses from the heart and muscles are uncomfortable for patients and dr ...Written By: Kara MarkerMAR 22, 2018Chemistry & PhysicsThe idea of adding artificial parts to biological bodies to create an “enhanced” being isn’t anything ...Written By: Daniel DuanMAR 21, 2018Clinical & Molecular DXSilent seizures often go unnoticed, but they can cause brain damage in certain cases. With proper diagnosis of this cond ...Written By: Kara MarkerMAR 19, 2018Clinical & Molecular DXCurrent tests for new “designer drugs” like fentanyl and synthetic cannabinoids are incompatible with emerge ...Written By: Kara MarkerMAR 07, 2018Clinical & Molecular DXDiagnostic tests for the Zika virus are only reliable in the three weeks following initial infection. That is, until now ...Written By: Kara MarkerMAR 05, 2018Clinical & Molecular DXMany children with a genetic disorder that predisposes them to kidney disease have to receive a kidney transplant before ...Written By: Kara MarkerMAR 01, 2018Clinical & Molecular DXScientists found evidence of the yellow fever virus in urine and semen samples for almost one month after one São ...Written By: Kara MarkerFEB 27, 2018Cell & Molecular BiologyA new method has been developed by scientists at the University of Texas Dallas that singles out aggressive cells that a ...Written By: Carmen LeitchFEB 21, 2018Clinical & Molecular DXA new imaging option makes it possible to diagnose breast cancer with better accuracy, improved efficiency, and with mor ...Written By: Kara MarkerFEB 15, 2018Cell & Molecular BiologyCRISPR technology continues to revolutionize biology; two new diagnostic tools based on the technique have now been deve ...Written By: Carmen LeitchFEB 15, 2018Clinical & Molecular DXA new device called the Blink Reflexometer™ could drastically improve field-side diagnostic capabilities used by a ...Written By: Kara MarkerFEB 13, 2018Clinical & Molecular DXDiagnosing a dangerous infection by a fungal yeast that often devastates hospital patients is now faster and more effici ...Written By: Kara MarkerJAN 18, 2018Clinical & Molecular DXExisting diagnostic tests for autism spectrum disorder (ASD) are highly subjective and in need of improvement. From Indi ...Written By: Kara MarkerJAN 10, 2018CardiologyScientists have a new test to calculate a person’s risk of early-onset heart disease, taking into account multiple ...Written By: Kara MarkerJAN 08, 2018Cell & Molecular BiologyNew work reveals that the chronic infections that impact CF patients may be vulnerable to some classes of antibiotics.Written By: Carmen LeitchJAN 03, 2018Clinical & Molecular DXA new way to calculate so-called “bad cholesterol” levels in the blood could eliminate inconvenient pre-test ...Written By: The Scripps Research Institute (TSRI)
APR 16, 2018
Genetics & Genomics
This discovery could help show why some people are more prone to developing the disorder.
Written By:
Carmen Leitch
APR 15, 2018
Drug Discovery & Development
A study published in Nature Medicine examines a monoclonal antibody isolated from the blood of individuals vaccinated fo
...
Written By:
Nouran Amin
APR 11, 2018
Cardiology
There’s a new biomarker in the world of science that finally links heart disease and diabetes on the molecular lev
...
Written By:
Kara Marker
APR 10, 2018
Cancer
A group in South Korea are conducting a clinical trial to evaluate a diagnostic screening tool for gastric cancer using
...
Written By:
Mauri Brueggeman
APR 06, 2018
Cancer
The Cancer Genome Atlas project used genomic profiles and bioinformatics to catalogue 33 prevalent types of cancer and i
...
Written By:
Mauri Brueggeman
APR 06, 2018
Clinical & Molecular DX
Diagnostic tests for Lyme disease, or Lyme neuroborreliosis (LNB) can take up to a week, but patients affected need anti
...
Written By:
Kara Marker
APR 04, 2018
Cancer
A group of researchers have proposed a new risk grouping model to more accurately/precisely predict the risk of prostate
...
Written By:
Mauri Brueggeman
MAR 29, 2018
Clinical & Molecular DX
A potential new diagnostic test for kidney damage associated with antibiotic use in cystic fibrosis (CF) patients is abl
...
Written By:
Kara Marker
MAR 28, 2018
Cardiology
Diagnostic electrodes for measuring electrical impulses from the heart and muscles are uncomfortable for patients and dr
...
Written By:
Kara Marker
MAR 22, 2018
Chemistry & Physics
The idea of adding artificial parts to biological bodies to create an “enhanced” being isn’t anything
...
Written By:
Daniel Duan
MAR 21, 2018
Clinical & Molecular DX
Silent seizures often go unnoticed, but they can cause brain damage in certain cases. With proper diagnosis of this cond
...
Written By:
Kara Marker
MAR 19, 2018
Clinical & Molecular DX
Current tests for new “designer drugs” like fentanyl and synthetic cannabinoids are incompatible with emerge
...
Written By:
Kara Marker
MAR 07, 2018
Clinical & Molecular DX
Diagnostic tests for the Zika virus are only reliable in the three weeks following initial infection. That is, until now
...
Written By:
Kara Marker
MAR 05, 2018
Clinical & Molecular DX
Many children with a genetic disorder that predisposes them to kidney disease have to receive a kidney transplant before
...
Written By:
Kara Marker
MAR 01, 2018
Clinical & Molecular DX
Scientists found evidence of the yellow fever virus in urine and semen samples for almost one month after one São
...
Written By:
Kara Marker
FEB 27, 2018
Cell & Molecular Biology
A new method has been developed by scientists at the University of Texas Dallas that singles out aggressive cells that a
...
Written By:
Carmen Leitch
FEB 21, 2018
Clinical & Molecular DX
A new imaging option makes it possible to diagnose breast cancer with better accuracy, improved efficiency, and with mor
...
Written By:
Kara Marker
FEB 15, 2018
Cell & Molecular Biology
CRISPR technology continues to revolutionize biology; two new diagnostic tools based on the technique have now been deve
...
Written By:
Carmen Leitch
FEB 15, 2018
Clinical & Molecular DX
A new device called the Blink Reflexometer™ could drastically improve field-side diagnostic capabilities used by a
...
Written By:
Kara Marker
FEB 13, 2018
Clinical & Molecular DX
Diagnosing a dangerous infection by a fungal yeast that often devastates hospital patients is now faster and more effici
...
Written By:
Kara Marker
JAN 18, 2018
Clinical & Molecular DX
Existing diagnostic tests for autism spectrum disorder (ASD) are highly subjective and in need of improvement. From Indi
...
Written By:
Kara Marker
JAN 10, 2018
Cardiology
Scientists have a new test to calculate a person’s risk of early-onset heart disease, taking into account multiple
...
Written By:
Kara Marker
JAN 08, 2018
Cell & Molecular Biology
New work reveals that the chronic infections that impact CF patients may be vulnerable to some classes of antibiotics.
Written By:
Carmen Leitch
JAN 03, 2018
Clinical & Molecular DX
A new way to calculate so-called “bad cholesterol” levels in the blood could eliminate inconvenient pre-test
...
Written By:
The Scripps Research Institute (TSRI)